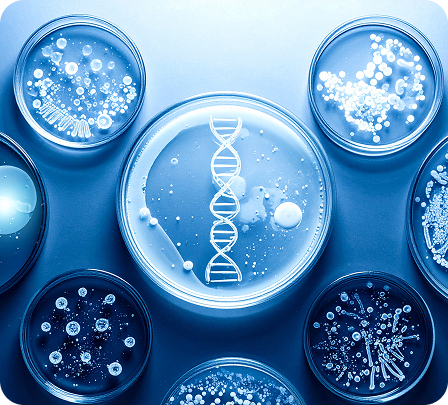

Product Categories
Unlock advanced biocosmetic solutions with Meteoric Cosmeceutiicals Private Limited. Our portfolio is founded on breakthrough research, smart technology, and nature’s finest resources, delivering transformative results for every individual need.
(Coming Soon)
Precision postbiotic actives that foster a balanced, resilient skin microbiome.
Pure, potent plant-based actives offering effective and naturally clean beauty care.
These help remove dead skin cells and promote skin renewal
Promote radiance and even skin tone
Improve elasticity, firmness, and overall youthfulness
Enhances skin brightness and clarity (melanin-balancing or tone-evening agents)
Target hyperpigmentation and uneven tone
Anti-inflammatory, sebum-controlling, or antimicrobial properties
Hydration, barrier repair, and moisture retention
Hair cuticle remodeling, shininess activation and hair friction decrease
Trusted & Certified Worldwide
Meteoric Cosmeceutiicals Pvt Ltd is committed to elevating the global standards of Biotech Beauty. Our advanced portfolio of BioCosmetics, Postbiotics and Cosmetic Botanicals is developed with rigorous scientific validation and strict quality assurance.
Recognized and trusted worldwide, we deliver high-performance, safe, and reliable solutions that meet the evolving demands of next-generation Biotech Beauty formulations.